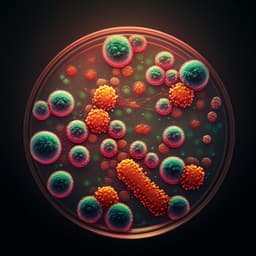
Can precision antibiotic prescribing help prevent the spread of carbapenem-resistant organisms in the hospital setting?

Environmental Studies and Forestry
Multidrug-resistant high-risk clonal *Escherichia coli* lineages occur along an antibiotic residue gradient in the Baltic Sea
P. Lübcke, S. E. Heiden, et al.
This groundbreaking study conducted by Phillip Lübcke and colleagues highlights the alarming presence of ESBL-producing *E. coli* in northeastern Germany's surface water. The research delves into antibiotic resistance, heavy metal tolerance, and potential reservoirs for these bacteria in the Baltic Sea, revealing critical insights about our water systems and public health.
~3 min • Beginner • English
Related Publications
Explore these studies to deepen your understanding of the subject.